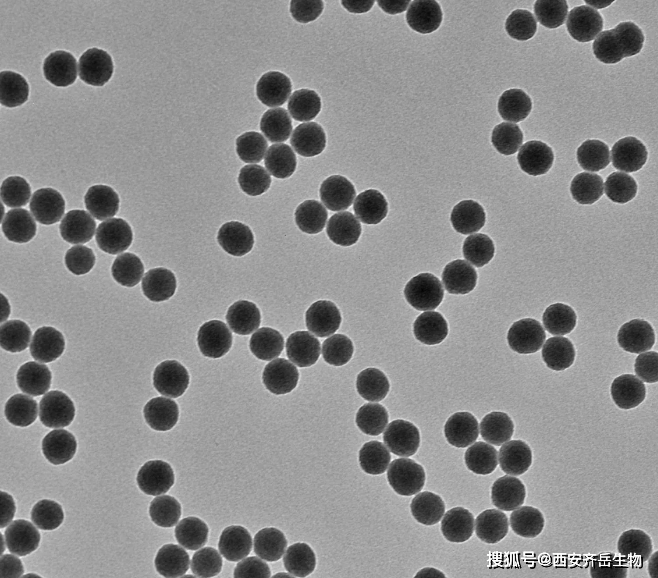
fe修饰的介孔sio2(fe-sio2)复合材料 定制合成_纳米_二氧化硅_领域

恶唑啉软膏

的eiichi fujita教授合作,报道了新的手性试剂——手性噁唑啉-2-硫酮
图片尺寸712x494
evans羟醛缩合反应_of_手性_产物
图片尺寸1080x421
《中国伴侣动物寄生虫地图-兽医快讯》-跳蚤_宠物_环境_猫狗
图片尺寸1080x762
113种常见疾病用药方法特别有用建议你收藏
图片尺寸462x486
共有1家生产厂家批发商
图片尺寸300x300
供应信息(全国)上海源叶生物科技有限公司产品名 :2-甲基苯并噁唑购买
图片尺寸530x271
3999三九皮炎平软膏20g湿疹皮炎皮肤瘙痒止痒的药膏抗过敏外用正品已
图片尺寸800x800
113种常见疾病用药方法特别有用建议你收藏
图片尺寸390x432
徽圣麦无忧:32%异丙隆-唑啉草.湘当好:8%二磺·炔·双氟可分.
图片尺寸216x171
113种常见疾病用药方法特别有用建议你收藏
图片尺寸350x582
小麦返青期除草有"四看",除草更干净,麦苗更安全,农户别犯错_腾讯新闻
图片尺寸908x600
fe修饰的介孔sio2(fe-sio2)复合材料 定制合成_纳米_二氧化硅_领域
图片尺寸658x578
上海交通大学张万斌课题组pdcu双金属协同催化的立体发
图片尺寸335x191
(s)-meo-biphep作为金属钯盐的配体,二茂铁噁唑啉配体l1作为金属铜
图片尺寸317x586
市面上很多成份都能对跳蚤有作用,目前异噁唑啉类药物是最新一代驱虫
图片尺寸831x930
113种常见疾病用药方法特别有用建议你收藏
图片尺寸400x500
史炳锋教授课题组ccschem基于双配体调控的钴催化不对
图片尺寸621x807
长沙理工大学罗维纬与周俊团队不对称合成轴手性杂芳基二胺化合物
图片尺寸660x367
金催化串联n烯基化与33σ重排反应合成2氨基1吡咯啉衍生物
图片尺寸660x1034
网易首页>网易号>正文申请入驻> 首先,作者以nh-异噁唑啉衍生物1a与炔
图片尺寸660x841